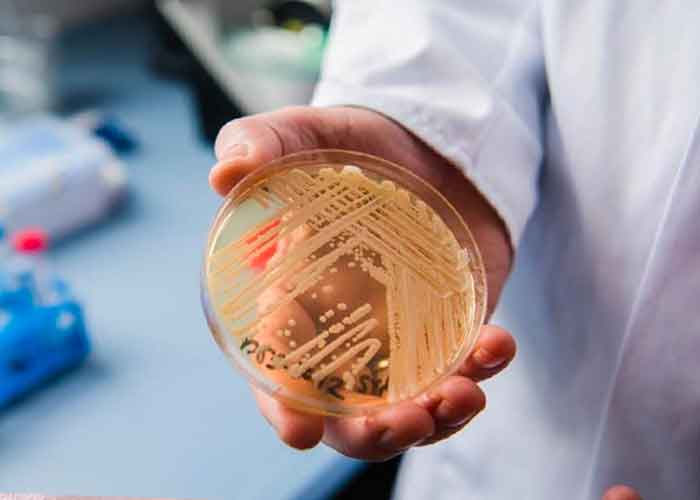
hongo-candida-el-salvador el salvador

Este lunes 22 de febrero, el médico Iván Solano Leiva informó a través de su cuenta de Twitter que El Salvador ya registra su primer caso de infección por Candida Auris, un hongo con alta resistencia a medicamentos, lo que representa un gran riesgo para la salud del país.
El caso fue identificado en un paciente del Hospital General del Instituto Salvadoreño del Seguro Social (ISSS), informó Solano. Además, instó a que las autoridades de Salud, el ministro Francisco Alabi y la directora del Seguro Social, Mónica Ayala, se pronuncien ante esta situación, la cual, para Solano y por recomendación de la Organización Panamericana de la Salud, es necesario declarar alerta epidemiológica.
Las autoridades de salud todavía no se pronuncian ante este hallazgo.
Te puede interesar: Encefalitis: ¿Qué es, síntomas, causas y prevención?
Crónicas Salud Pública: se confirma X CDC de USA 1er caso infección X Candida auris en ??. Siguiendo recomendaciones de OPS, es necesario declaración de Alerta Epidemiológica X @SaludSV y escuchar al Sr. Ministro @FranAlabi y Sra. Directora @isss_gob_sv @MonicaAyalaGue1 pic.twitter.com/7sjKo0rejY
— Ivan Solano Leiva (@solano_leiva) February 22, 2021
Hongo Candida Auris en Guatemala
La segunda semana de febrero, Guatemala declaró alerta epidemiológica en el país luego de haber detectado el primer caso de infección por este hongo, Candida Auris.
Este hongo se trata de una levadura emergente, un descubrimiento nuevo en su especie. Su efecto en el cuerpo humano puede ser fatal, sobre todo para las personas con un sistema inmune debilitado y es capaz de causar graves infecciones en órganos y tejidos. También puede llegar a causar candidemia, una infección severa en la sangre.
También puedes ver: Flamencos en Chipre podrían estar siendo envenenados
Expertos han señalado que podría tratarse de una próxima pandemia debido a los siguientes factores: su resistencia a los fármacos, dificultad para identificarlo con los métodos de laboratorio estándar y porque ha llegado a causar brotes sanitarios.
El Centro para el Control y la Prevención de Enfermedades (DCD), de EUA, ha informado que este nuevo hongo puede propagarse mayoritariamente en entornos de atención médica, a través de contacto con superficies contaminadas o de persona a persona. Pero hasta el momento, las investigaciones en torno al mismo continúan.